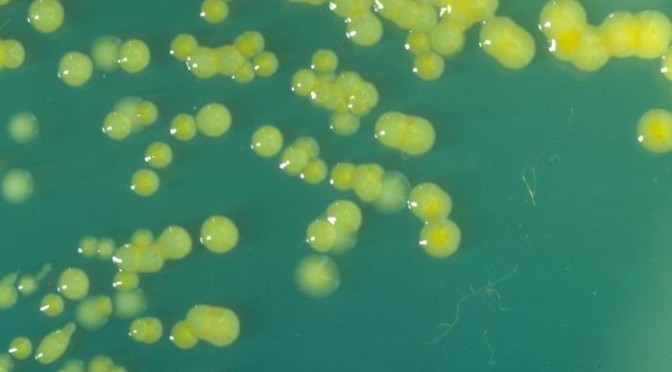

Compañía estadounidense retira 53 productos del mercado por contaminación bacteriológica
USA.- La empresa Lyons Magnus emitió un comunicado a través de la Administración de Alimentos y Medicamentos (Food and Drug Administration, FDA por sus siglas en inglés), el pasado viernes 29 de julio anunciando el retiro del mercado de 53 productos por posible contaminación con Cronobacter sakazakii, bacteria del género Enterobacter que se aloja en el intestino.
Esta bacteria puede introducirse por vía oral, contacto directo o mediante la ingesta de alimentos contaminados, la cual puede provocar una infección peligrosa de la sangre (septicemia). También puede causar la inflamación del recubrimiento alrededor del cerebro y la médula espinal (meningitis).
Los más susceptibles a los efectos de esta bacteria son los bebés menores a los 2 meses de nacidos quienes pueden desarrollar meningitis por la bacteria cronobacter. Asimismo, los bebés nacidos prematuros y con sistemas inmunológicos debilitados también pueden enfermarse de gravedad por esta bacteria.
Dentro de la lista de productos retirados por Lyons Magnus se incluyen lotes de bebidas, café líquido, suplementos nutricionales pediátricos, batidos de proteínas, batidos nutricionales y líquidos espesados. Los productos contaminados pertenecen a las marcas Oatly, Stumptown, Glucerna, Intelligentsia, Aloha, Kate Farms y Premier Protein.
Con información de saludiario.com